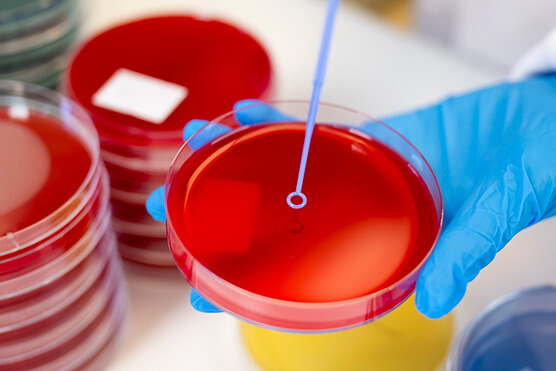
Royal College of Pathologists
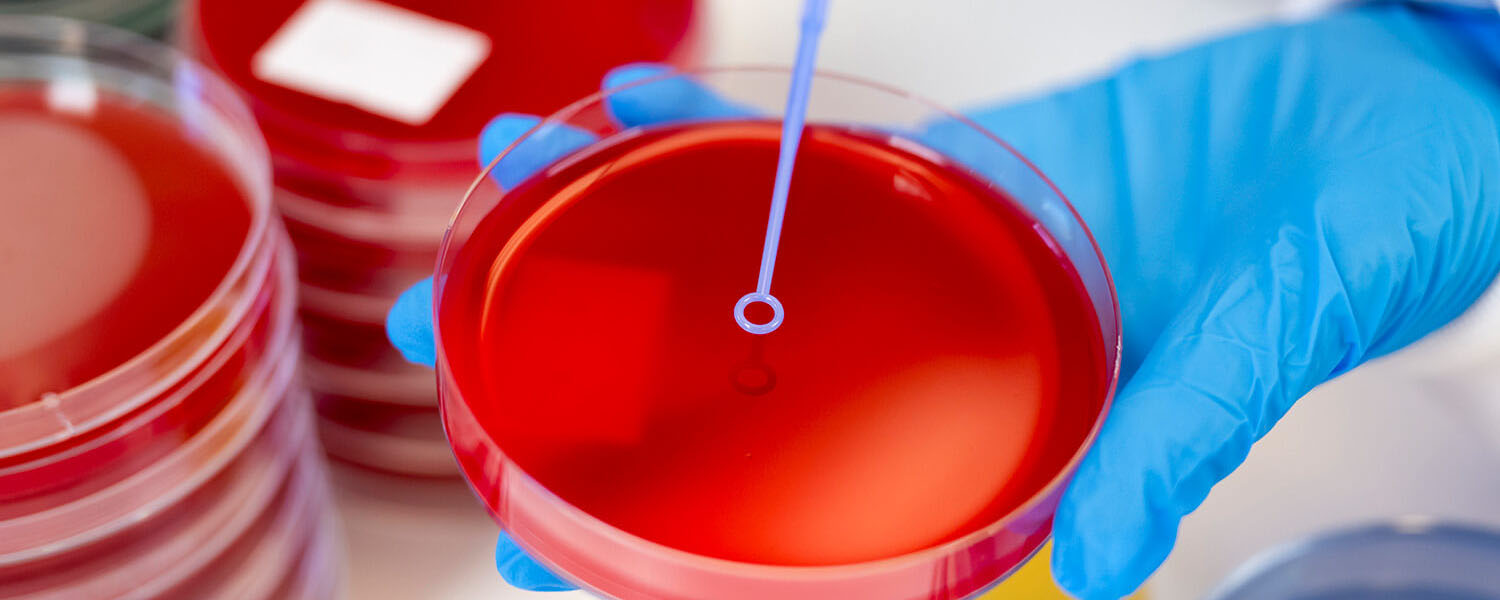
hospital lab photo

HEATHCARE PHOTOGRAPHY
Healthcare Photographer Simon Vine
Producing quality images for public, private and charity sectors.
HEALTHCARE
Public & Private Sectors
Simon is experienced shooting in the healthcare sector, on location in hospitals, surgeries, dental practises, care homes and with other medical healthcare providers.
Working in a clinical setting is often a challenge as they are busy environments, time limited to produce the professional photography and working in a safe manner. It’s important to put people at ease to get the most out of a photography session.
Simon is a member of the Commercial Photographers Network; clients include BUPA, Anchor Housing and national care home providers.
Simon always works safely, see Heath & Safety Policy here.

CARE HOME PHOTOGRAPHY
Regional & National Coverage
Simon is highly experienced in shooting professional images for the care home sector, for websites, social media, advertising and marketing.
It’s always important to put residents and staff at ease to get the most out of a photography session. Photography in clinical care settings is often a challenge, they are busy environments, which can including dementia care or special needs support which have to be carefully considered.
Simon is a member of the Commercial Photographers Network; clients include well known National Care Home providers.
HEALTHCARE PORTFOLIO








images copyright © simon vine
Case Studies

Lansinoh
Healthcare marketing and advertising photography of Lansinoh pregnancy, postpartum & baby products.
Royal College of Pathologists
Website & communications photography of hospital laboratories in the North of England
LOCATION
Based in Leeds, Simon Vine Photographer is geographically well placed to provide professional healthcare photography across the North of England, Yorkshire and Humberside. Including the cities of Leeds, Bradford, Wakefield, York, Sheffield, Doncaster, Hull, Manchester and Liverpool. Also Simon regularly travels around the UK on projects, working as required, day or night.
PROFILE
Experienced 20 Years+
Full Public Liability Insurance
DBS Checked
GDPR & Health & Safety are taken seriously
PPE used when required